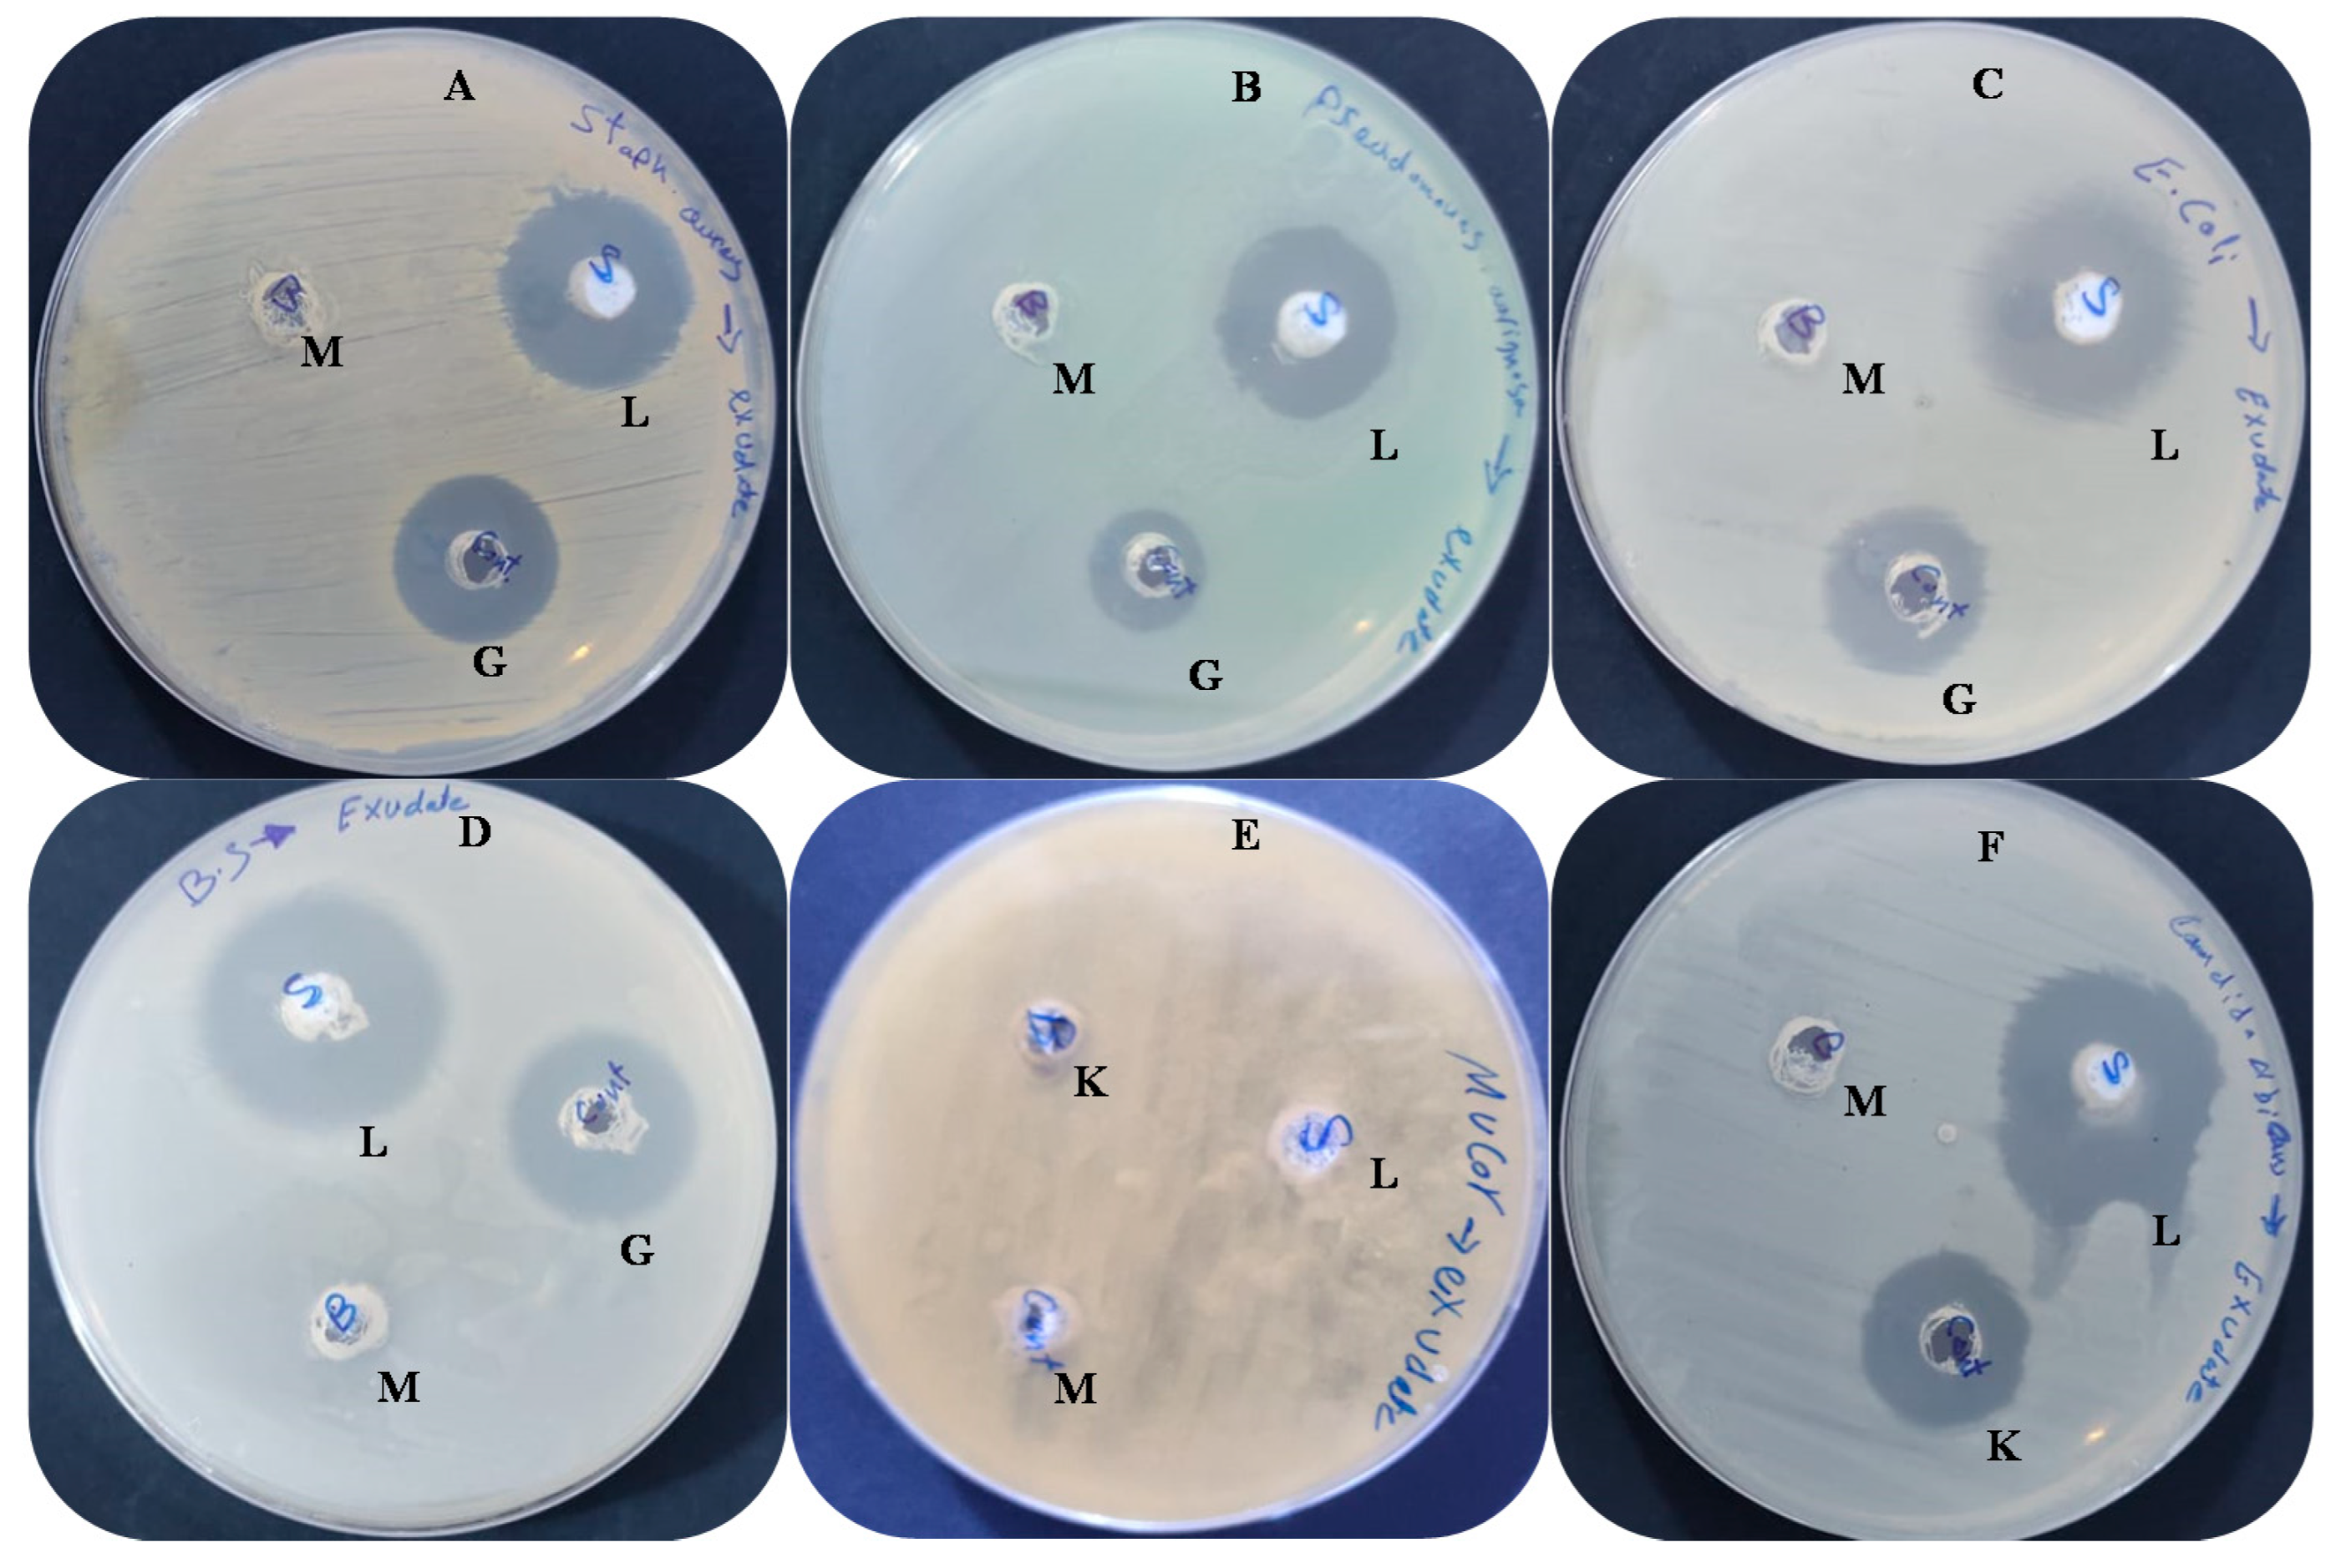
Molecules 27 03165 g003

Anticancer, Anticoagulant, Antioxidant and Antimicrobial Activities of Thevetia peruviana Latex with Molecular Docking of Antimicrobial and Anticancer Activities
Abstract
1. Introduction
2. Materials and Methods
2.1. Collection of Thevetia peruviana Latex
2.2. Flavonoid and Phenolic Analysis of Thevetia peruviana Latex by HPLC
2.3. DPPH Radical Scavenging Protocol for Detecting the Antioxidant Activity
2.4. Antimicrobial Activity and Minimum Inhibitory Concentration (MIC) Detection
2.5. Ultrastructure Examination of the Exposed Bacteria to Latex
2.6. Coagulation Assay In Vitro
2.7. Preparation of Erythrocyte and Hypotonicity Induced Haemolysis
2.8. Cell Lines and Cytotoxicity Assay
2.9. Molecular Docking
2.10. Statistical Analysis
3. Results and Discussion
3.1. Analysis of Phytoconstituents
3.2. Antimicrobial Activity and Ultrastructure Changes
3.3. Antioxidant Activity
3.4. Antihemolysis Activity
3.5. Anticoagulant Activity
3.6. Anticancer Activity
3.7. Molecular Docking Study
4. Conclusions
Author Contributions
Funding
Institutional Review Board Statement
Informed Consent Statement
Data Availability Statement
Acknowledgments
Conflicts of Interest
Sample Availability
References
- Agrawal, A.A.; Konno, K. Latex: A model for understanding mechanisms, ecology and evolution of plant defense against herbivory. Annu. Rev. Ecol. Evol. Syst. 2009, 40, 311–331. [Google Scholar] [CrossRef]
 - Siritapetawee, J.; Thammasirirak, S.; Samosornsuk, W. Antimicrobial activity of a 48-kDa protease (AMP48) from Artocarpus heterophyllus latex. Eur. Rev. Med. Pharmacol. Sci. 2012, 16, 132–137. [Google Scholar] [PubMed]
 - Abdel Ghany, T.M. Safe food additives: Review. J. Biol. Chem. Res. 2015, 32, 402–437. [Google Scholar]
 - Konno, K. Plant latex and other exudates as plant defense systems: Roles of various defense chemicals and proteins contained therein. Phytochemistry 2011, 72, 1510–1530. [Google Scholar] [CrossRef] [PubMed]
 - De Freitas, C.D.T.; Da Cruz, W.T.; Silva, M.Z.R.; Vasconcelos, I.M.; Moreno, F.B.M.B.; Moreira, R.D.A.; Monteiro-Moreira, A.C.; Alencar, L.M.R.; Sousa, J.S.; Rocha, B.A.M.; et al. Proteomic analysis and purification of an unusual germin-like protein with proteolytic activity in the latex of Thevetia peruviana. Planta 2016, 243, 1115–1128. [Google Scholar] [CrossRef]
 - Raghavendra, R.; Mahadevan, G.D. In Vitro Antimicrobial Activity of Various Plant Latex against Resistant Human Patho-gens. Int. J. Pharm. Pharm. Sci. 2011, 3, 70–72. [Google Scholar]
 - Che S, I.S.; Basri, M.; Fard Masoumi, H.R.; Chee, W.J.; Ashari, S.E.; Ismail, M. Effects of Temperature, Time, and Solvent Ratio on the Extraction of Phenolic Compounds and the Anti-Radical Activity of Clinacanthus nutans Lindau Leaves by Response Surface Methodology. Chem. Cent. J. 2017, 11, 54. [Google Scholar]
 - Ahmad, T.; Hamid, A.T.; Sharma, A.; Bhardwaj, U. Thevetia peruviana: A Multipurpose Medicinal Plant—A Review. Int. J. Adv. Res. 2017, 5, 486–493. [Google Scholar] [CrossRef]
 - Tinpun, K.; Nakpheng, T.; Padmavathi, A.R.; Srichana, T. In Vitro Studies of Jatropha curcas L. Latex Spray Formulation for Wound Healing Applications. Turk. J. Pharm. Sci. 2020, 17, 271–279. [Google Scholar] [CrossRef]
 - Monavari, S.H.; Shahrabadi, M.S.; Keyvani, H.; Bokharaei-Salim, F. Evaluation of In Vitro Antiviral Activity of Chelidonium majus L. against Herpes Simplex Virus Type-1. Afr. J. Microbiol. Res. 2012, 6, 4360–4364. [Google Scholar]
 - Gardin, N.E.; Braga, A.J. Greater Celandine (Chelidonium majus L.) for COVID-19: A Twenty-Case Series. Phytother. Res. 2021, 35, 3792–3798. [Google Scholar] [CrossRef] [PubMed]
 - Gracz-Bernaciak, J.; Mazur, O.; Nawrot, R. Functional Studies of Plant Latex as a Rich Source of Bioactive Compounds: Focus on Proteins and Alkaloids. Int. J. Mol. Sci. 2021, 22, 12427. [Google Scholar] [CrossRef] [PubMed]
 - Brito, E.S.A.; Prado, L.D.P.T.; Araújo, L.K.C.; Arnhold, E.; Matos, M.P.C.; de Paula, J.A.M.; Ramos, L.M.; Fonseca-Alves, C.E.; de Moura, V.M.B.D. Effects of the Latex of Synadenium grantii Hook F. (Euphorbiaceae) on a Preclinical Model of Canine Prostate Cancer. Front. Vet. Sci. 2021, 8, 605286. [Google Scholar] [CrossRef] [PubMed]
 - Gour, A.; Manhas, D.; Bag, S.; Gorain, B.; Nandi, U. Flavonoids as potential phytotherapeutics to combat cytokine storm in SARS-CoV-2. Phytother. Res. 2021, 35, 4258–4283. [Google Scholar] [CrossRef]
 - Tripathi, A.; Misra, K. Molecular docking: A structure-based drug designing approach. JSM Chem. 2017, 5, 1042–1046. [Google Scholar]
 - Yuliya, S.; Prokopenko, Y.S.; Lina, O.; Perekhoda, L.O.; Victoriya, A.; Georgiyants, V.A. Docking studies of biologically active sub-stances from plant extracts with anticonvulsant activity. J. Appl. Pharm. Sci. 2019, 9, 66–72. [Google Scholar]
 - Hagel, J.M.; Yeung, E.C.; Facchini, P.J. Got milk? The secret life of laticifers. Trends Plant Sci. 2008, 13, 631–639. [Google Scholar] [CrossRef]
 - Abdelghany, T.M.; Yahya, R.; Bakri, M.M.; Ganash, M.; Amin, B.H.; Qanash, H. Effect of Thevetia peruviana Seeds Extract for Microbial Pathogens and Cancer Control. Int. J. Pharmacol. 2021, 17, 643–655. [Google Scholar] [CrossRef]
 - Abdelghany, T.M.; Ganash, M.; Alawlaqi, M.M.; Al-Rajhi, A.M.H. Antioxidant, Antitumor, Antimicrobial Activities Evaluation of Musa paradisiaca L. Pseudostem Exudate Cultivated in Saudi Arabia. BioNanoScience 2019, 9, 172–178. [Google Scholar] [CrossRef]
 - Abdelghany, T.M. Stachybotrys chartarum: A novel biological agent for the extracellular synthesis of silver nanoparticles and their antimicrobial activity. Indones. J. Biotechnol. 2013, 18, 75–82. [Google Scholar]
 - Fana, L.; Wua, P.; Zhanga, J.; Gaoa, S.; Wanga, L.; Li, M.; Shaa, M.; Weiguo Xie, W.; Nie, M. Synthesis and anticoagulant activi-ty of the quaternary ammonium chitosan sulfates. Int. J. Biol. Macromol. 2012, 50, 31–37. [Google Scholar] [CrossRef]
 - Meziti, H.; Bouriche, H.; Kada, S.; Demirtas, I.; Kizil, M.; Senator, A.; Garrido, G. Phytochemical analysis, and antioxidant, anti-hemolytic and genoprotective effects of Quercus ilex L. and Pinus halepensis Mill. methanolic extracts. J. Pharm. Pharmacogn. Res. 2019, 7, 260–272. [Google Scholar]
 - Qanash, H.; Yahya, R.; Bakri, M.M.; Bazaid, A.S.; Qanash, S.; Shater, A.F.; Abdelghany, T.M. Anticancer, antioxidant, antiviral and antimicrobial activities of Kei Apple (Dovyalis caffra) fruit. Sci. Rep. 2022, 12, 5914. [Google Scholar] [CrossRef]
 - Alam, M.A.; Subhan, N.; Rahman, M.M.; Uddin, S.J.; Reza, H.M.; Sarker, S.D. Effect of Citrus Flavonoids, Naringin and Naringenin, on Metabolic Syndrome and Their Mechanisms of Action. Adv. Nutr. 2014, 5, 404–417. [Google Scholar] [CrossRef]
 - Satari, A.; Ghasemi, S.; Habtemariam, S.; Asgharian, S.; Lorigooini, Z. Rutin: A Flavonoid as an Effective Sensitizer for Anticancer Therapy; Insights into Multifaceted Mechanisms and Applicability for Combination Therapy. Evid. -Based Complement. Altern. Med. 2021, 2021, 9913179. [Google Scholar] [CrossRef]
 - Srivastava, S.; Somasagara, R.R.; Hegde, M.; Nishana, M.; Tadi, S.K.; Srivastava, M.; Choudhary, B.; Raghavan, S.C. Quercetin, a Natural Flavonoid Interacts with DNA, Arrests Cell Cycle and Causes Tumor Regression by Activating Mitochondrial Pathway of Apoptosis. Sci. Rep. 2016, 6, 24049. [Google Scholar] [CrossRef]
 - Colunga, B.R.M.L.; Berrill, M.; Catravas, J.D.; Marik, P.E. Quercetin and Vitamin C: An Experimental, Synergistic Therapy for the Prevention and Treatment of SARS-CoV-2 Related Disease (COVID-19). Front. Immunol. 2020, 11, 1451. [Google Scholar] [CrossRef] [PubMed]
 - Rahman, F.; Tabrez, S.; Ali, R.; Alqahtani, A.S.; Ahmed, M.Z.; Rub, A. Molecular docking analysis of rutin reveals possible inhibition of SARS-CoV-2 vital proteins. J. Tradit. Complement. Med. 2021, 11, 173–179. [Google Scholar] [CrossRef] [PubMed]
 - Di Matteo, G.; Spano, M.; Grosso, M.; Salvo, A.; Ingallina, C.; Russo, M.; Ritieni, A.; Mannina, L. Food and COVID-19: Preventive/Co-therapeutic Strategies Explored by Current Clinical Trials and in Silico Studies. Foods 2020, 9, 1036. [Google Scholar] [CrossRef] [PubMed]
 - Choi, J.-H.; Kim, S. Investigation of the anticoagulant and antithrombotic effects of chlorogenic acid. J. Biochem. Mol. Toxicol. 2017, 31, e21865. [Google Scholar] [CrossRef]
 - Yan, Y.; Zhou, X.; Guo, K.; Zhou, F.; Yang, H. Use of Chlorogenic Acid against Diabetes Mellitus and Its Complications. J. Immunol. Res. 2020, 2020, 9680508. [Google Scholar] [CrossRef] [PubMed]
 - Mihanfar, A.; Darband, S.G.; Sadighparvar, S.; Kaviani, M.; Mirza-Aghazadeh-Attari, M.; Yousefi, B.; Majidinia, M. In Vitro and In Vivo Anticancer Effects of Syringic Acid on Colorectal Cancer: Possible Mechanistic View. Chem. Interact. 2021, 337, 109337. [Google Scholar] [CrossRef] [PubMed]
 - Aref, H.L.; Gaaliche, B.; Fekih, A.; Mars, M.; Aouni, M.; Chaumon, J.P.; Said, K. In Vitro Cytotoxic and Antiviral Activities of Ficus carica Latex Extracts. Nat. Prod. Res. 2011, 25, 310–319. [Google Scholar] [CrossRef] [PubMed]
 - Sibi, G.; Wadhavan, R.; Singh, S.; Shukla, A.; Dhananjaya, K.; Ravikumar, K.R.; Mallesha, H. Plant Latex: A Promising Antifungal Agent for Post Harvest Disease Control. Pak. J. Biol. Sci. 2013, 16, 1737–1743. [Google Scholar] [CrossRef]
 - Walsh, S.E.; Maillard, J.-Y.; Russell, A.D.; Catrenich, C.E.; Charbonneau, D.L.; Bartolo, R.J. Activity and mechanisms of action of selected biocidal agents on Gram-positive and -negative bacteria. J. Appl. Microbiol. 2003, 94, 240–247. [Google Scholar] [CrossRef]
 - Upadhyay, R.K. Antimicrobial Activity of Fruit Latexes from Ten Laticiferous Plants. Am. J. Plant Sci. 2015, 6, 483–499. [Google Scholar] [CrossRef][Green Version]
 - Siritapetawee, J.; Limphirat, W.; Wongviriya, W.; Maneesan, J.; Samosornsuk, W. Isolation and characterization of a galactose-specific lectin (EantH) with antimicrobial activity from Euphorbia antiquorum L. latex. Int. J. Biol. Macromol. 2018, 120, 1846–1854. [Google Scholar] [CrossRef]
 - Shahinuzzaman, M.; Yaakob, Z.; Anuar, F.H.; Akhtar, P.; Kadir, N.; Hasan, A.; Sobayel, K.; Nour, M.; Sindi, H.; Amin, N.; et al. In Vitro Antioxidant Activity of Ficus carica L. Latex from 18 Different Cultivars. Sci. Rep. 2020, 10, 10852. [Google Scholar] [CrossRef]
 - Samrot, A.V.; Sea, T.C. Investigating the Antioxidant and Antimicrobial Activity of Artocarpus heterophyllus Lam. (Jackfruit) Latex. Biointerface Res. Appl. Chem. 2022, 12, 3019–3033. [Google Scholar] [CrossRef]
 - Kumar, V.L.; Roy, S. Calotropis procera Latex Extract Affords Protection against Inflammation and Oxidative Stress in Freund's Complete Adjuvant-Induced Monoarthritis in Rats. Mediat. Inflamm. 2007, 2007, 47523. [Google Scholar] [CrossRef]
 - Rahman, N.; Rahman, H.; Haris, M.; Mahmood, R. Wound healing potentials of Thevetia peruviana: Antioxidants and inflammatory markers criteria. J. Tradit. Complement. Med. 2017, 7, 519–525. [Google Scholar] [CrossRef] [PubMed]
 - Osoniyi, O.; Onajobi, F. Coagulant and anticoagulant activities in Jatropha curcas latex. J. Ethnopharmacol. 2003, 89, 101–105. [Google Scholar] [CrossRef]
 - Félix-Silva, J.; Souza, T.; Camara, R.B.; Cabral, B.; Silva-Júnior, A.A.; Rebecchi, I.M.; Zucolotto, S.M.; Rocha, H.A.; Fernandes-Pedrosa, M. In Vitro Anticoagulant and Antioxidant Activities of Jatropha Gossypiifolia L. (Euphorbiaceae) Leaves Aiming Therapeutical Applications. BMC Complement. Altern. Med. 2014, 14, 405. [Google Scholar] [CrossRef]
 - Asare, F.; Koffuor, G.A.; Nyansah, W.B.; Gyanfosu, L.; Abruquah, A.A. Anticoagulant and antiplatelet properties of the latex of unripe fruits of Carica papaya L. (Caricaceae). Int. J. Basic Clin. Pharmacol. 2015, 4, 1183–1188. [Google Scholar] [CrossRef]
 - Khuraishi, A.M.; Jayalakshmi, M.S.; Harini, A.; Kunder, A.S.; Mahesh, M. Isolation and purification of anticoagulant enzymes from plant latex. J. Appl. Nat. Sci. 2019, 11, 217–222. [Google Scholar] [CrossRef]
 - Choedon, T.; Mathan, G.; Arya, S.; Kumar, V.L. Anticancer and cytotoxic properties of the latex of Calotropis procera in a transgenic mouse model of hepatocellular carcinoma. World J. Gastroenterol. 2006, 12, 2517–2522. [Google Scholar] [CrossRef]
 - Mousinho, K.C.; Oliveira, C.D.C.; Ferreira, J.R.; Carvalho, A.A.; Magalhães, H.I.; Bezerra, D.P.; Alves, A.P.; Costa-Lotufo, L.V.; Pessoa, C.; de Matos, M.P.; et al. Antitumor effect of laticifer proteins of Himatanthus drasticus (Mart.) Plumel—Apocynaceae. J. Ethnopharmacol. 2011, 137, 421–426. [Google Scholar] [CrossRef] [PubMed]
 - Amaral, R.G.; Gomes, S.V.F.; Andrade, L.N.; Dos Santos, S.A.; Severino, P.; de Albuquerque Júnior, R.L.C.; Souto, E.B.; Brandão, G.C.; Santos, S.L.; David, J.M.; et al. Cytotoxic, Antitumor and Toxicological Profile of Passiflora alata Leaf Extract. Molecules 2020, 25, 4814. [Google Scholar] [CrossRef]
 - Farah, M.A.; Al-Qahtani, M.A.; Abou-Tarboush, F.M.; Al-Anazi, K.M.; Al-Harbi, N.O.; Ali, M.A.; Hailan, W.A.Q. Anticancer effects of Calotropis procera latex extract in mcf-7 breast cancer cells. Pharmacogn. Mag. 2020, 16, 550–556. [Google Scholar] [CrossRef]
 - Saida, L.; Tulasi, C.D.S.L.N.; Narasu, M.L. Evaluation of chemo-preventive efficacy of Ficus religiosa latex extract by flow cytometry analysis and gene expression studies performed by RT-PCR in various cell lines. Future J. Pharm. Sci. 2021, 7, 37. [Google Scholar] [CrossRef]

| Flavonoids | Phenolic Acids | ||||
|---|---|---|---|---|---|
| RT * | Compound | Concentration (µg/mL) | RT * | Compound | Concentration (µg/mL) | 
| 4.4 | Naringin | 5.25 | 3 | Chlorogenic acid | 12.39 | 
| 5.3 | Rutin | 11.45 | 5 | Syringenic acid | 7.45 | 
| 7.0 | Quercetin | 7.15 | 7 | Benzoic acid | 3.55 | 
| 8.1 | Kaempferol | 4.65 | 9 | Pyrogallol | 2.78 | 
| 9.0 | Luteolin | 5.02 | 11 | Ferulic acid | 5.07 | 
| 10.0 | Hisperdin | 6.07 | 13 | Cinnamic acid | 2.44 | 
| 12.0 | Catechin | 4.17 | |||
| Tested Microorganisms | Inhibition Zone (mm) | MIC µg/mL | ||
|---|---|---|---|---|
| Extract (100 µL) | Control * | |||
| Gr + ve bacteria | S. aureus | 25.33 ± 0.20 | 20.20 ± 0.23 | 7.80 ± 0.05 | 
| B. subtilis | 31.25 ± 0.33 | 25.10 ± 0.21 | 10.20 ± 0.12 | |
| Gr-ve bacteria | E. coli | 30.33 ± 0.50 | 21.21 ± 0.20 | 12.51 ± 0.05 | 
| P. aeruginosa | 23.21 ± 0.40 | 15.02 ± 0.21 | 15.62 ± 0.04 | |
| Fungi | C. albicans | 28.02 ± 0.05 | 23.04 ± 0.06 | 15.50 ± 0.33 | 
| M. circinelloides | 0.0 ± 0.00 | 0.0 ± 0.00 | 0.0 ± 0.00 | |
| Concentration μg/mL | PC-3 | MCF-7 | ||||||
|---|---|---|---|---|---|---|---|---|
| Mean O.D | SE | Viability% | Toxicity% | Mean O.D | SE | Viability% | Toxicity% | |
| Control | 0.554 | 0.010 | 100 | 0.00 | 0.476 | 0.010 | 100 | 0.00 | 
| 31.25 | 0.39 | 0.008 | 69.80 | 30.20 | 0.30 | 0.006 | 62.11 | 37.89 | 
| 62.5 | 0.15 | 0.011 | 26.71 | 73.29 | 0.13 | 0.008 | 26.75 | 73.25 | 
| 125 | 0.06 | 0.009 | 11.43 | 88.57 | 0.02 | 0.001 | 3.43 | 96.57 | 
| 250 | 0.02 | 0.004 | 4.40 | 95.61 | 0.02 | 0.001 | 3.29 | 96.71 | 
| 500 | 0.017 | 0.001 | 3.07 | 96.93 | 0.02 | 0.001 | 3.36 | 96.64 | 
| 1000 | 0.02 | 0.001 | 2.89 | 97.11 | 0.02 | 0.001 | 3.78 | 96.23 | 
| IC50 | 48.26 μg/mL | 40.31 μg/mL | ||||||
| Atoms/Ring | Chlorogenic Acid Interaction with 7C7N Protein | |||
|---|---|---|---|---|
| Receptor | Interaction | Distance | E (kcal/mol) | |
| O 39 | OD2 ASP 73 (A) | H-donor | 2.79 | −4.8 | 
| O 15 | NH1 ARG 76 (A) | H-acceptor | 3.00 | −0.6 | 
| O 23 | NH2 ARG 136 (A) | H-acceptor | 3.13 | −7.2 | 
| O 22 | NH2 ARG 76 (A) | Ionic | 3.05 | −4.2 | 
| Atoms/Ring | Rutin interaction with 3QUM protein | |||
| O 47 | O PRO 146 (P) | H-donor | 2.98 | −0.6 | 
| O 64 | NE ARG 38 (P) | H-acceptor | 3.24 | −1.2 | 
| O 66 | NE ARG 38 (P) | H-acceptor | 3.07 | −0.5 | 
| 6-ring | NH1 ARG 60 (P) | Pi-Cation | 4.94 | −0.5 | 
| Atoms/Ring | Rutin interaction with 1JNX protein | |||
| O 11 | O LEU 1854 (X) | H-donor | 2.91 | −1.6 | 
| O 45 | O THR 1852 (X) | H-donor | 2.95 | −1.7 | 
| O 68 | O VAL 1740 (X) | H-donor | 2.95 | −1.3 | 
| Compound | Receptor | Mol. | S | Rmsd_Refine | E_Conf | E_Place | E_Score 1 | E_Refine | E_Score 2 | 
|---|---|---|---|---|---|---|---|---|---|
| Chlorogenic Acid | 7C7N | ![]()  | −6.0422 | 0.9533 | −14.1250 | −47.7348 | −8.7382 | −35.4672 | −6.0422 | 
| Rutin | 3QUM | ![]()  | −6.8798 | 1.8680 | 140.3166 | −92.8697 | −11.6206 | −42.6250 | −6.8798 | 
| Rutin | 1JNX | ![]()  | −6.9797 | 1.5443 | 128.9704 | −27.3114 | −8.6365 | −43.6968 | −6.9797 | 
Publisher’s Note: MDPI stays neutral with regard to jurisdictional claims in published maps and institutional affiliations.  | 
© 2022 by the authors. Licensee MDPI, Basel, Switzerland. This article is an open access article distributed under the terms and conditions of the Creative Commons Attribution (CC BY) license (https://creativecommons.org/licenses/by/4.0/).
Share and Cite
Al-Rajhi, A.M.H.; Yahya, R.; Abdelghany, T.M.; Fareid, M.A.; Mohamed, A.M.; Amin, B.H.; Masrahi, A.S. Anticancer, Anticoagulant, Antioxidant and Antimicrobial Activities of Thevetia peruviana Latex with Molecular Docking of Antimicrobial and Anticancer Activities. Molecules 2022, 27, 3165. https://doi.org/10.3390/molecules27103165
Al-Rajhi AMH, Yahya R, Abdelghany TM, Fareid MA, Mohamed AM, Amin BH, Masrahi AS. Anticancer, Anticoagulant, Antioxidant and Antimicrobial Activities of Thevetia peruviana Latex with Molecular Docking of Antimicrobial and Anticancer Activities. Molecules. 2022; 27(10):3165. https://doi.org/10.3390/molecules27103165
Chicago/Turabian StyleAl-Rajhi, Aisha M. H., Reham Yahya, Tarek M. Abdelghany, Mohamed A. Fareid, Alawlaqi M. Mohamed, Basma H. Amin, and Abdurrahman S. Masrahi. 2022. "Anticancer, Anticoagulant, Antioxidant and Antimicrobial Activities of Thevetia peruviana Latex with Molecular Docking of Antimicrobial and Anticancer Activities" Molecules 27, no. 10: 3165. https://doi.org/10.3390/molecules27103165
APA StyleAl-Rajhi, A. M. H., Yahya, R., Abdelghany, T. M., Fareid, M. A., Mohamed, A. M., Amin, B. H., & Masrahi, A. S. (2022). Anticancer, Anticoagulant, Antioxidant and Antimicrobial Activities of Thevetia peruviana Latex with Molecular Docking of Antimicrobial and Anticancer Activities. Molecules, 27(10), 3165. https://doi.org/10.3390/molecules27103165
        
                                                

       

